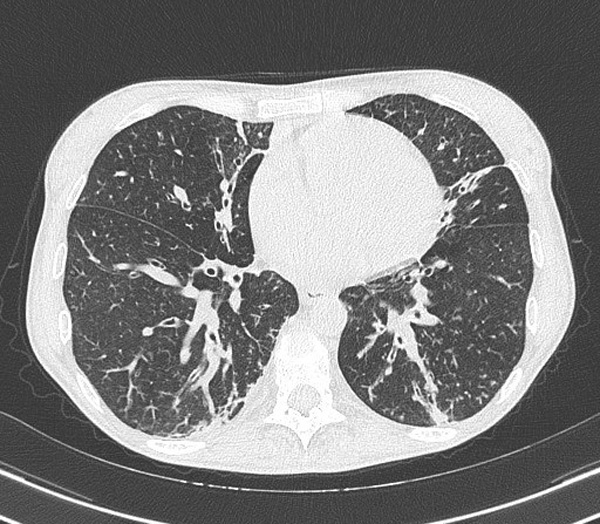
Image658635.PNG

Pulmonary Complications in a Patient with Common Variable Hypogammaglobulinemia
Paolo Ghiringhelli 1, Fabrizio Foieni 1, Girolamo Sala 1, Alessandro Diana 1, Beatrice Valvo 1, Mariella Ciola 1, Michele Zaza 1, Roberto Bertolini 2, Cinzia Simoni 2, Lorenzo Bellintani 1, Andrea Agostinelli 1, Federica Macchi 1, Sara Limbiati 1, Michela Provisione1
1 Medicina Interna, Ospedale di Circolo di Busto Arsizio, ASST Valle Olona, Italy
2 Medicina Interna, Ospedale di Gallarate, ASST Valle Olona, Italy
Abstract
Common variable immunodeficiency (CVID) is a rare disorder characterized by primary antibody deficiency leading to hypogammaglobulinemia and increased risk of infections. Pulmonary hypertension (PH) is an unusual complication of CVID and may be associated with chronic hypoxemic respiratory failure.
We described the case of a 47-year-old female patient hospitalized with worsening dyspnea, which had emerged about 10 days before and was associated with productive cough. 26 years before, she was diagnosed with common variable hypogammaglobulinemia, that was treated with intravenous immunoglobulin infusions for at least 20 years. She had suffered from recurrent secondary infections of the respiratory tract with inveterate bronchiectasis, pulmonary hypertension, and chronic respiratory failure.
This case suggests that Internal Medicine wards, due to their global vision of the patient, are well suited to manage subjects with serious, complex, and genetically determined pathologies.
Keywords: Common Variable Hypogammaglobulinemia; Respiratory Failure; Pulmonary Hypertension
CMI 2023; 17(1): 1-7
http://doi.org/10.7175/cmi.v17i1.1521
Case Report
Why Do we Describe This Case
This case underlines the importance of correcting chronic hypoxemia with adequate long-term oxygen therapy in patients with common variable immunodeficiency and pulmonary hypertension
Introduction
Common variable immunodeficiency (CVID) is a rare immune system disorder characterized by primary antibody deficiency that leads to hypogammaglobulinemia. It affects between 1:25,000 and 1:196,000 patients worldwide and is usually diagnosed during the age range 20–45 years, although it can be identified earlier [1]. The cause is unknown, but a genetic mutation has been identified in around 10% of cases [2]. The diagnosis is based on biologic examinations and the differential diagnosis with other causes of hypogammaglobulinemia. In case of CVID, serum levels of immunoglobulin (Ig) G are below the age-adjusted reference range on two samples more than 3 weeks apart (or on a single measurement if their level is very low) [3]. The levels of immunoglobulins A and/or M also are decreased. Infectious complications are the main manifestations, mostly affecting respiratory tract and lungs and frequently resulting in the development of bronchiectasis. In addition, CVID patients can develop autoimmune, lymphoproliferative, and inflammatory complications. In recent years, several cases of CVID have been reported to be associated with elevations in pulmonary artery pressures [4-7]. Treatment is based on intravenous or subcutaneous Ig replacement therapy.
Patients with rare diseases are necessarily managed by dedicated centers, but sometimes they are referred to Internal Medicine wards, thus allowing an adequate monitoring of rare disease-related pathologies and complications arising from rare disease-related predispositions.
Case Presentation
A 47-year-old female patient, known for thalassemia trait and glucose-6-phosphate dehydrogenase deficiency was admitted to the Internal Medicine ward for respiratory failure in August 2021.
In 1996, the diagnosis of common variable hypogammaglobulinemia associated with functional deficit of T lymphocytes was made and since then she has been in replacement treatment with monthly infusion of immunoglobulins. She reported repeated infectious episodes of the upper and lower respiratory tract in her remote medical history. She also reported previous laparotomy for appendectomy and hemoperitoneum from hemorrhagic corpus luteum and multiple hospitalizations for muscle and paravertebral abscess localizations subjected to surgical toilet and external drainage. In 2006, she underwent splenectomy and partial pancreatectomy for multiple abscess collections. For some years, she was known for multifactorial pulmonary hypertension and at admission she was in therapy with macitentan and sildenafil. In March 2020, she was hospitalized for SARS-CoV-2 pneumonia.
In her last visit in the Rare Disease Center, in April 2021, clinical stability was reported and her pulmonary hypertension was categorized as World Health Organization (WHO) class I. Furthermore, home O2 was prescribed, but self-suspended thereafter due to reasons associated with subjective wellbeing. The problem was no longer evaluated.
On the 17th of August 2021, she was sent to the Emergency Department by her general practitioner due to worsening dyspnea and low-grade fever for about 10 days and associated with productive cough. Blood tests showed high levels of white blood cells (WBCs) and C-reactive protein (CRP) (Table I).
|
Parameter |
Detected level |
Normal range |
|
WBC (n/L) |
22.050 |
4000–10,000 |
|
RBC (×106/μL) |
5.77* |
3.6–5.3 |
|
CRP (mg/dL) |
6 |
<0.5 |
|
Hb (g/dL) |
12.3 |
11.0–15.0 |
|
Globular volume (fL) |
74.1** |
80–96 |
|
Neutrophil granulocytes (%) |
56.1 |
40–74 |
|
Lymphocytes (%) |
38.2 |
19–48 |
|
Monocytes (%) |
4.4 |
3.4–9.0 |
|
Eosinophilic granulocytes (%) |
0.8 |
0–7 |
|
Basophilic granulocytes (%) |
0.4 |
0–1.5 |
|
Platelets (×103/μL) |
817** |
150–400 |
|
Creatinine (mg/dL) |
0.74 |
0.51–0.95 |
|
ALT (IU/L) |
18 |
8–41 |
|
Total bilirubin (mg/dL) |
0.25 |
<1.2 |
|
Lactate dehydrogenase (IU/L) |
163 |
125–220 |
|
Total protein (g/dL)* |
5.6 |
6.0–8.0 |
|
IgM (mg/dL)** |
<5 |
40–230 |
|
IgA (mg/dL)** |
<5 |
70–400 |
|
IgG (mg/dL)* |
215 |
700–1600 |
Table I. Patient’s clinical parameters at admission, in August 2021.
ALT = alanine transaminase; CRP = C-reactive protein; Hb = hemoglobin; RBC = red blood cells; WBC = white blood cells
*pathological;
**severely pathological
Chest X-ray (Figure 1) and chest CT (Figure 2), compared with the previous tests available, showed an unchanged picture of bilateral bronchiolitis characterized by millimetric center-lobular nodulations partly confluent and by thickening areas located in the medial segment of the middle lobe, in the lingula and in the postero-basal regions of both lower lobes, with greater extension to the left. Instead, a small, faint left retrocardiac thickening had appeared. Therefore, at ward admission, the patient was diagnosed with lower respiratory tract infection, with partial respiratory failure, in a CVID picture.

Figure 1. Chest X-ray performed in August 2021.
SX = left
Figure 2. Chest CT performed in August 2021.
Therapy with amoxicillin and clavulanate 2 g every 8 hours was prescribed, together with oxygen therapy (first at 8 L/min for a simple mask, subsequently at 3 L/min).
Once clinically stabilized, the patient showed the following gas analysis values in room air: pH = 7.31; pO2 = 49 mmHg; pCO2 = 36 mmHg; SO2 = 83%; and HCO3- = 18 mEq. Therefore, the residual hypoxemia was secondary not to the respiratory inflammation, now in resolution, but to the pulmonary hypertension.
After monitoring the nocturnal oximetry and the gait test, the oxygen prescription at discharge was optimized to 3 L/min at rest and 5 L/min during exercise. Transthoracic echocardiogram during hospitalization showed that systolic pressure in pulmonary artery (PAPs) was equal to 65 mmHg.
Two months later, she was evaluated in outpatient’s clinic; she was autonomous and compliant with the prescribed oxygen therapy. She also had resumed going out, by carrying an 8-liter liquid oxygen stroller, that gave her the possibility to stay outside for a few hours.
Discussion
CVID, a primary antibody deficiency characterized by hypogammaglobulinemia, is known to cause infectious, inflammatory, and autoimmune manifestations. CVID is not a single disease but rather a collection of hypogammaglobulinemia syndromes resulting from many genetic defects. In about 25% of cases, specific molecular defects have been identified, although in most patients, the causes are unknown [8]. CVID has been defined, as in our patient, by the following laboratory criteria [8,9]:
Pulmonary hypertension (PH) is an unusual complication of CVID, with largely unknown characteristics. The underlying mechanisms have been described recently [4,6].
In many patients, the diagnosis of PH is made thanks to a variety of clinical findings and non-invasive tests. For example, a clinical diagnosis is commonly made in patients with PH due to significant left heart disease (LHD) or chronic lung disease (CLD). Conversely, some patients require hemodynamic diagnosis by right heart catheterization (RHC; e.g., patients with suspected idiopathic pulmonary arterial hypertension—PAH) as recommended by the 2015 ESC/ERS Guidelines [10]. Precapillary PH is defined as mean pulmonary arterial pressure (mPAP) ≥25 mmHg, pulmonary arterial wedge pressure (PAWP) ≤15 mmHg, and pulmonary vascular resistance (PVR) ≥3 Wood units (WU).
CVID-associated PH is characterized by precapillary PH and is included in group 5 of the current PH classification (Box 1).
Box 1. Clinical classification of PH. Modified from [10]
1. PAH
1.1. Idiopathic PAH
1.2. Heritable PAH
1.3. Drug- and toxin-induced PAH
1.4. PAH associated with:
1.4.1. Connective tissue disease
1.4.2. HIV infection
1.4.3. Portal hypertension
1.4.4. Congenital heart disease
1.4.5. Schistosomiasis
1.5. PAH long-term responders to calcium channel blockers
1.6. PAH with overt features of venous/capillaries (PVOD/PCH) involvement
1.7. Persistent PH of the newborn syndrome
2. PH due to left heart disease
2.1. PH due to heart failure with preserved LVEF
2.2. PH due to heart failure with reduced LVEF
2.3. Valvular heart disease
2.4. Congenital/acquired cardiovascular conditions leading to post-capillary PH
3. PH due to lung diseases and/or hypoxia
3.1. Obstructive lung disease
3.2. Restrictive lung disease
3.3. Other lung disease with mixed restrictive/obstructive pattern
3.4. Hypoxia without lung disease
3.5. Developmental lung disorders
4. PH due to pulmonary artery obstructions
4.1. Chronic thromboembolic PH
4.2. Other pulmonary artery obstructions
5. PH with unclear and/or multifactorial mechanisms
5.1. Hematological disorders
5.2. Systemic and metabolic disorders
5.3. Others
5.4. Complex congenital heart disease
LVEF = left ventricular ejection fraction; PAH = pulmonary arterial hypertension; PCH = pulmonary capillary hemangiomatous; PH = pulmonary hypertension; PVOD = pulmonary veno-occlusive disease
In 2018, our patient had undergone right heart catheterization at the University of Pavia, following the echocardiographic finding of severe pulmonary hypertension (60 mmHg).
Echocardiography is used to detect elevated pulmonary artery systolic pressures (ePASP) as well as altered right-sided ventricle structure or dysfunction and evidence of left-sided heart disease. However, the definition of mild, moderate, and severe PH on echocardiography is ill-defined (and the cut-offs are somewhat arbitrary). In addition, echocardiography can be misleading, particularly in those with advanced lung disease [11,12]. Right cardiac catheterization confirmed the presence of moderate pre-capillary pulmonary hypertension (34 mmHg) in accordance with the international classification, which includes 3 classes of severity [13-15] (Table II).
|
Echocardiography ePASP |
Pulmonary artery catheter mPAP (mmHg) |
|
Mild |
|
|
≥20 and <40 |
≥25* and <30 |
|
Moderate |
|
|
≥40 and <60 |
≥30 and <35 |
|
Severe |
|
|
≥60 |
≥35 OR ≥25 and elevated RA pressure and/or CI<2 L/min/m2 |
Table II. Pulmonary hypertension severity. Modified from [15].
CI = cardiac index; ePASP = estimated pulmonary artery systolic pressure; mPAP = mean pulmonary artery pressure; RA = right atrial
* Those with mPAP between 20 and 24 mmHg are considered to have borderline elevations in PAP of uncertain significance
The patient’s alveolar capillary diffusion, associated with alveolar ventilation, was severely impaired (38%) and correlated, as described in the literature, with the severity of PH [16].
In our patient, the pathogenesis of PH is complex. In fact, there are pulmonary causes belonging to group 3 and lesser-known causes probably associated with the known CVID.
The prevalence of group 3 PH varies depending on the underlying disease and its severity, with rates ranging from 20% to 90%. Most patients in group 3 PH have mild-to-moderate elevations in mean pulmonary artery pressure (e.g., mPAP 25 to 34 mmHg) [17] (Table II). In contrast, to patients with group 1 pulmonary arterial hypertension (PAH), few patients in group 3 PH (<5%) have severe PH (mPAP ≥35 mmHg or mPAP ≥25 mmHg and elevated right atrial pressure and/or a cardiac index <2 L/min/m2). The severity of PH appears to correlate with the severity of the underlying disorder [18].
In a recent study by Thore et al. [4], CVID-associated PH seems to be a late complication of the disease (arising in a median time of 12 years). In that court, Authors estimate that PH occurs in at least 0.37% of CVID patients, but they assume that the actual value should probably be much higher since screening for PH in CVID patients is not routinely performed due to the multifactorial nature of dyspnea in this population. This factor must be considered by physicians working in Internal Medicine, who sometimes supervise these patients if Expert Centers are far and may first suspect CVID as a new diagnosis [4].
Its pathophysiological mechanisms are still unknown, but it seems to be due to the inflammatory nature of CVID: pulmonary vascular remodeling, pulmonary parenchymal involvement, extrinsic compression by mediastinal lymphadenopathies, and portal hypertension [10].
Clinical evaluation of the patient and the rate of change over time are also indicative of prognosis. In this regard, the WHO has issued a specific classification (Table III).
|
Class |
WHO functional classification |
|
I |
Patients with pulmonary hypertension but without resulting limitations of physical activity. Ordinary physical activity does not cause undue fatigue or dyspnea, chest pain, or heart syncope. |
|
II |
Patients with pulmonary hypertension resulting in slight limitation of physical activity. They are comfortable at rest. Ordinary physical activity results in undue fatigue or dyspnea, chest pain, or heart syncope. |
|
III |
Patients with pulmonary hypertension but without resulting in marked limitations of physical activity. They are comfortable at rest. Less than ordinary physical activity cause undue fatigue or dyspnea, chest pain, or heart syncope. |
|
IV |
Patients with pulmonary hypertension resulting in inability to carry on any physical activity without symptoms. These patients manifest signs of right heart failure. Dyspnea and/or fatigue may be present even at rest. Discomfort is increased by physical activity. |
Table III. Pulmonary hypertension WHO classification. Modified from [19].
WHO = World Health Organization
By analyzing Table III, it is clear that our patient belongs to the second class. It is important to preserve the performance status as much as possible.
In the care of our patient, oxygen therapy is crucial, but respiratory physiotherapy is also important.
Not many studies have been published in the literature where the various techniques of physio-kinesiotherapy (PKT) and their efficacy in non-cystic fibrosis (CF) bronchiectasis have been evaluated. For this reason, their indication is often extrapolated from other researchs, such as those published on CF and chronic obstructive pulmonary disease (COPD) [20,21]. Some caution is always required in importing these techniques into the therapeutic plan of patients suffering from non-CF bronchiectasis, due to the pathophysiological differences between the various diseases where they have been used [22,23].
The most described PKT techniques are:
Conclusions
The presence of chronic hypoxemia worsens and exacerbates the pathogenetic mechanisms of precapillary pulmonary hypertension; hence, the importance of correcting chronic hypoxemia with proper long-term oxygen therapy with adequate flow at rest, under exertion and at night.
Respiratory physiotherapy, especially if assisted, motivates the patient to remove secretions that obstruct the airways.
Key points
References
1. Gathmann B, Mahlaoui N; CEREDIH; Gérard L, et al. European Society for Immunodeficiencies Registry Working Party. Clinical picture and treatment of 2212 patients with common variable immunodeficiency. J Allergy Clin Immunol 2014; 134: 116-26; https://doi.org/10.1016/j.jaci.2013.12.1077
2. Sullivan KE, Puck JM, Notarangelo LD, et al. USIDNET: a strategy to build a community of clinical immunologists. J Clin Immunol 2014; 34: 428-35; https://doi.org/10.1016/10.1007/s10875-014-0028-1
3. Quinti I, Soresina A, Spadaro G, et al. Long-term follow-up and outcome of a large cohort of patients with common variable immunodeficiency. J Clin Immunol 2007; 27: 308-16; https://doi.org/10.1007/s10875-007-9075-1
4. Thoré P, Jaïs X, Savale L, et al. Pulmonary Hypertension in Patients with Common Variable Immunodeficiency. J Clin Immunol 2021; 41: 1549-62; https://doi.org/10.1007/s10875-021-01064-w
5. Thoré P, Humbert M, Montani D. Pulmonary hypertension: A rare but severe complication of common variable immunodeficiency. Ann Allergy Asthma Immunol 2021; 127: 512-3; https://doi.org/10.1016/j.anai.2021.06.016
6. Daniil Z, Karetsi E, Zakynthinos E, et al. Pulmonary arterial hypertension in a patient with common variable immunodeficiency and unilateral bronchiectasis: Successful treatment with iloprost. Eur J Intern Med 2007; 18: 333-5; https://doi.org/10.1016/j.ejim.2006.11.014
7. Arslan S, Ucar R, Yavsan DM, et al. Common variable immunodeficiency and pulmonary amyloidosis: a case report. J Clin Immunol 2015; 35: 344-7; https://doi.org/10.1007/s10875-015-0151-7
8. Seidel MG, Kindle G, Gathmann B, et al. The European Society for Immunodeficiencies (ESID) Registry Working Definitions for the Clinical Diagnosis of Inborn Errors of Immunity. J Allergy Clin Immunol Pract 2019; 7: 1763; https://doi.org/10.1016/j.jaip.2019.02.004
9. Bonilla FA, Barlan I, Chapel H, et al. International Consensus Document (ICON): Common Variable Immunodeficiency Disorders. J Allergy Clin Immunol Pract 2016; 4: 38; https://doi.org/10.1016/j.jaip.2015.07.025
10. Simonneau G, Montani D, Celermajer DS, et al. Haemodynamic definitions and updated clinical classification of pulmonary hypertension. Eur Respir J 2019; 53: 1801913; https://doi.org/10.1183/13993003.01913-2018
11. D’Andrea A, Stanziola A, Di Palma E, et al. Right Ventricular Structure and Function in Idiopathic Pulmonary Fibrosis with or without Pulmonary Hypertension. Echocardiography 2016; 33: 57; https://doi.org/10.1111/echo.12992
12. Nowak J, Hudzik B, Jastrzȩbski D, et al. Pulmonary hypertension in advanced lung diseases: Echocardiography as an important part of patient evaluation for lung transplantation. Clin Respir J 2018; 12: 930; https://doi.org/10.1111/crj.12608
13. Stone AC, Machan JT, Mazer J, et al. Echocardiographic evidence of pulmonary hypertension is associated with increased 1-year mortality in patients admitted with chronic obstructive pulmonary disease. Lung 2011; 189: 207; https://doi.org/10.1007/s00408-011-9293-4
14. Seeger W, Adir Y, Barberà JA, et al. Pulmonary hypertension in chronic lung diseases. J Am Coll Cardiol 2013; 62: D109; https://doi.org/10.1016/j.jacc.2013.10.036
15. Galiè N, Humbert M, Vachiery JL, et al. 2015 ESC/ERS Guidelines for the diagnosis and treatment of pulmonary hypertension: The Joint Task Force for the Diagnosis and Treatment of Pulmonary Hypertension of the European Society of Cardiology (ESC) and the European Respiratory Society (ERS): Endorsed by: Association for European Paediatric and Congenital Cardiology (AEPC), International Society for Heart and Lung Transplantation (ISHLT). Eur Respir J 2015; 46: 903-75; https://doi.org/10.1183/13993003.01032-2015
16. Hamada K, Nagai S, Tanaka S, et al. Significance of pulmonary arterial pressure and diffusion capacity of the lung as prognosticator in patients with idiopathic pulmonary fibrosis. Chest 2007; 131: 650; https://doi.org/10.1378/chest.06-1466
17. Budev MM, Arroliga AC, Wiedemann HP, et al. Cor pulmonale: an overview. Semin Respir Crit Care Med 2003; 24: 233; https://doi.org/10.1055/s-2003-41105
18. Kimura M, Taniguchi H, Kondoh Y, et al. Pulmonary hypertension as a prognostic indicator at the initial evaluation in idiopathic pulmonary fibrosis. Respiration 2013; 85: 456; https://doi.org/10.1159/000345221
19. Rich S. Primary pulmonary hypertension: executive summary. Evian, France. World Health Organization, 1998
20. Hurdman J, Condliffe R, Elliot CA, et al. Pulmonary hypertension in COPD: results from the ASPIRE registry. Eur Respir J 2013; 41: 1292; https://doi.org/10.1183/09031936.00079512
21. Oswald-Mammosser M, Weitzenblum E, Quoix E, et al. Prognostic factors in COPD patients receiving long-term oxygen therapy. Importance of pulmonary artery pressure. Chest 1995; 107: 1193; https://doi.org/10.1378/chest.107.5.1193
22. Weitzenblum E, Schrijen F, Mohan-Kumar T, et al. Variability of the pulmonary vascular response to acute hypoxia in chronic bronchitis. Chest 1988; 94: 772; https://doi.org/10.1378/chest.94.4.772
23. Snijders D, Fernandez Dominguez B, Calgaro S, et al. Mucociliary clearance techniques for treating non-cystic fibrosis bronchiectasis: Is there evidence? Int J Immunopathol Pharmacol 2015; 28: 150-9; https://doi.org/10.1177/0394632015584724